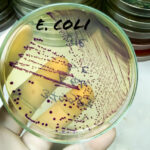

Users Cheer as Microsoft Accidentally Removes Hated AI Feature From Windows 11
Microsoft has “unintentionally uninstalled” its Copilot AI assistant app on some devices running its latest operating system Windows 11 — […]
Users Cheer as Microsoft Accidentally Removes Hated AI Feature From Windows 11 Read Post »